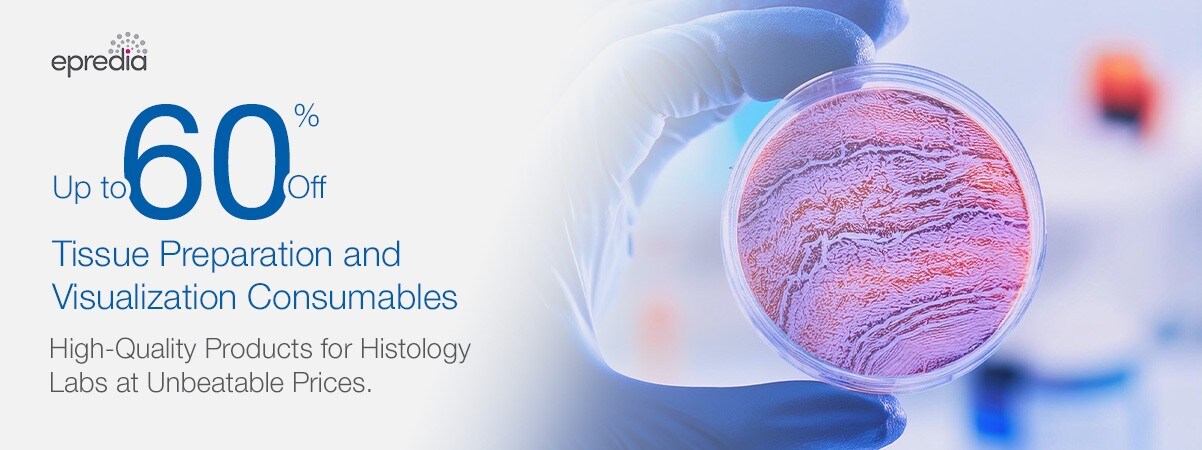
Epredia Epredia

Consumables for Tissue Preparation and Vizualisation
Boost Your Histology Efficiency With Up to 60% Off on Tissue Preparation and Visualization Consumables
Discover High-Quality, Lab-Tested Products at Unbeatable Prices – Limited Time Offer.
Histology labs rely on precision and reliability, and we're here to support your critical work. For a limited time, enjoy up to 60% off our wide range of consumables for tissue preparation and visualization. Whether you’re working with cutting-edge imaging or fine-tuning your tissue processing workflows, we’ve got everything you need.
Use promo code 21628 to access the special prices until 31st October 2024.*